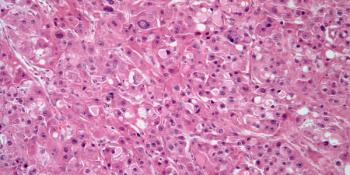
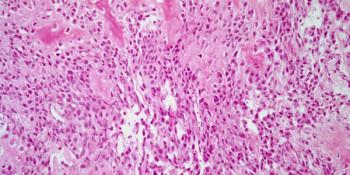

A 58-year-old man presents with a skin lesion, and a biopsy is performed. What is your diagnosis?

A 58-year-old man presents with a skin lesion, and a biopsy is performed. What is your diagnosis?

A 37-year-old woman is found to have an enlarged thyroid gland, and a biopsy is performed. What is your diagnosis?

A 43-year-old man presents with abdominal pain and diarrhea, and a gastric biopsy is obtained. What is your diagnosis?

A 34-year-old man presents with a dermal lesion, and a biopsy is performed. What is your diagnosis?

A 45-year-old man presents with symptoms of hypercalcemia. A neck mass is found, and a biopsy is performed. What is your diagnosis?

A 42-year-old man presents with a mass in his left leg, and a biopsy is performed. What is your diagnosis?

A 39-year-old woman presents with a parotid gland mass, and a biopsy is performed. What is your diagnosis?

A 47-year-old woman presents with right-sided pleural thickening, and a biopsy is performed. What is your diagnosis?

A 25-year-old woman presents with reddish nodules on her right foot, and a biopsy is performed. What is your diagnosis?

A 62-year-old woman is found to have a kidney mass, and a biopsy is performed. What is your diagnosis?

A 27-year-old man presents with a bone tumor, and a biopsy is performed. What is your diagnosis?

A prostate biopsy is obtained from a 56-year-old man. What is your diagnosis?

A 38-year-old man presents with a tumor in the epididymis, and a biopsy is performed. What is your diagnosis?

A 49-year-old man presents with a lesion on the right side of his chest, and a biopsy is performed. What is your diagnosis?

A 56-year-old man presents with a liver mass, and a biopsy is performed. What is your diagnosis?

A 52-year-old man presents with a lesion on one of his lower eyelids, and a biopsy is performed. What is your diagnosis?

A 47-year-old man presents with a penile lesion, and a biopsy is performed. What is your diagnosis?
A 36-year-old patient presents with a liver mass, and a biopsy is performed. What is your diagnosis?

A 30-year-old woman presents with a lesion at the base of her tongue, and a biopsy is performed. What is your diagnosis?

A 48-year-old woman presents with a lesion in the left breast, and a biopsy is performed. What is your diagnosis?

A 1-year-old child presents with leukocoria, and a biopsy is performed. What is your diagnosis?

A 46-year-old man presents with a nasal mass, and a biopsy is performed. What is your diagnosis?
A 38-year-old man presents with a mass of the right maxilla, and a biopsy is performed. What is your diagnosis?

A 37-year-old woman presents with a thyroid mass, and a biopsy is performed. What is your diagnosis?

A 47-year-old woman presents with a conjunctival mass of the left eye, and a biopsy is performed. What is your diagnosis?

A 44-year-old woman presents with vaginal bleeding, and an endocervical biopsy is obtained. What is your diagnosis?

A 57-year-old man presents with a superficial nodule on his right calf, and a biopsy is performed. What is your diagnosis?

A 38-year-old man presents with sweating and nausea. Imaging shows a mass in the adrenal gland, and a biopsy is performed. What is your diagnosis?

A 38-year-old man presents with a pigmented lesion on his back, and a biopsy is performed. What is your diagnosis?

A 47-year-old man presents with a cough and dyspnea. A bronchial mass in found, and a biopsy is performed. What is your diagnosis?